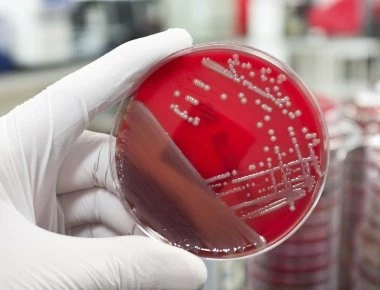
Συναγερμός στις ΗΠΑ για μυστηριώδη ασθένεια που προκαλεί παράλυση

Κόσμος
-
Nov- 2018 -13 NovemberΚόσμος
Συναγερμός στις ΗΠΑ για μυστηριώδη ασθένεια που προκαλεί παράλυση
Σε κατάσταση συναγερμού έχει τεθεί το Κέντρο Ελέγχου Ασθενειών (CDC) των ΗΠΑ καθώς πλέον έχει επιβεβαιώσει 90 κρούσματα μιας εξαιρετικά επικίνδυνης ασθένειας σε 27 Πολιτείες.Η ασθένεια ονομάζεται οξεί...
Read More » -
13 NovemberΚόσμος

«Εικόνες Αποκάλυψης» στην Καλιφόρνια: Οι φλόγες έσβησαν από το χάρτη το Paradise - 6.500 σπίτια έγιναν στάχτη
Για πέμπτη συνεχόμενη ημέρα χιλιάδες πυροσβέστες δίνουν υπεράνθρωπη μάχη με τις πυρκαγιές στην Καλιφόρνια, την ώρα που οι ομάδες έρευνας προσπαθούν να βρουν τις σορούς πιθανόν νέων θυμάτων στα αποκαΐδ...
Read More » -
13 NovemberΚόσμος

Φρίκη - Σκότωσε με τόξο την έγκυο πρώην του μπροστά στα μάτια των πέντε παιδιών της (φωτό, βίντεο)
Με τόξο επιτέθηκε στην πρώην σύζυγό του ένας άνδρας σκοτώνοντάς την, ενώ έπλενε τα πιάτα, μπροστά στα μάτια των πέντε παιδιών της. Η γυναίκα, που ήταν έγκυος στον όγδοο μήνα, έπεσε νεκρή ενώ διακομίστ...
Read More » -
13 NovemberΚόσμος

Σφοδρή αντίδραση Μπόρις Τζόνσον για συμφωνία για το BREXIT: «Γινόμαστε αποικία»!
Κατά της συμφωνίας για το Brexit που ετοιμάζουν η Τερέζα Μέι και η Ευρωπαϊκή Ένωση είναι ο Μπόρις Τζόνσον.Ο πρώην υπουργός Εξωτερικών της Βρετανίας έγραψε στο twitter πως «κανείς δεν ξεγελιέται από αυ...
Read More » -
13 NovemberΚόσμος

Έκτακτη σύγκληση του ΣΑ του ΟΗΕ για τη Γάζα ζητούν Κουβέιτ και Βολιβία
Το Κουβέιτ και η Βολιβία ζήτησαν τη σύγκληση κεκλεισμένων των θυρών του Συμβουλίου Ασφαλείας των Ηνωμένων Εθνών σήμερα για το τελευταίο κύμα συγκρούσεων μεταξύ ένοπλων παλαιστινιακών οργανώσεων και το...
Read More » -
13 NovemberΚόσμος

Ο πρωτότυπος τρόπος που η Ιαπωνία «γιορτάζει» την αυτοκρατορική διαδοχή
Το υπουργικό συμβούλιο του Ιάπωνα πρωθυπουργού Σίνζο Άμπε ενέκρινε την Τρίτη νομοσχέδιο που θεσπίζει 10ήμερη «χρυσή» αργία για την αυτοκρατορική διαδοχή που έχει προγραμματιστεί την επόμενη χρονιά.Σύμ...
Read More » -
13 NovemberΚόσμος

Τρομαχτικές εικόνες από Σιβηρία: H στιγμή που «τσουνάμι χιονιού» καταβροχθίζει πόλη - Δείτε βίντεο
Αν βρισκόμασταν στον φανταστικό κόσμο του Game of Thrones, η εικόνα ενός απίστευτου χιονιά να έρχεται κατά πάνω μας σαν να θέλει να μας καταβροχθίσει μπορεί και να ήταν φυσιολογική.Οι κάτοικοι του Κρα...
Read More » -
13 NovemberΚόσμος

Σκέψεις του Βαρθολομαίου να δώσει αυτοκεφαλία στην Κανονική Εκκλησία της Ουκρανίας
Το ενδεχόμενο να δώσει αυτοκεφαλία στην Κανονική Εκκλησία της Ουκρανίας του Πατριαρχείου Μόσχας και τον Μητροπολίτη Ονούφριο εξετάζει ο Οικουμενικός Πατριάρχης Βαρθολομαίος.Ο Οικουμενικός Πατριάρχης Β...
Read More » -
13 NovemberΚόσμος

Έκτακτη συνεδρίαση του βρετανικού υπουργικού συμβουλίου: Μονογράφουν την συμφωνία για το BREXIT
Έκτακτη συνεδρίαση του υπουργικού συμβουλίου της Βρετανίας θα πραγματοποιηθεί αύριο την Τετάρτη, για να υπογραφεί η συμφωνία Βρυξελλών – Λονδίνου για το Brexit, σύμφωνα με βρετανικά μέσα ενημέρωσης.Πρ...
Read More » -
13 NovemberΚόσμος

Συνάντηση Πούτιν - Θάτσι: Πικρία στο Βελιγράδι, ικανοποίηση στην Πρίστινα
Ο πρόεδρος της Σερβίας Αλεξάνταρ Βούτσιτς προσπάθησε να υποβαθμίσει την συνάντηση Πούτιν - Θάτσι προχθές στο Παρίσι στο περιθώριο των εκδηλώσεων για τα εκατό χρόνια από το τέλος του Α΄ Παγκόσμιου Πολέ...
Read More »
